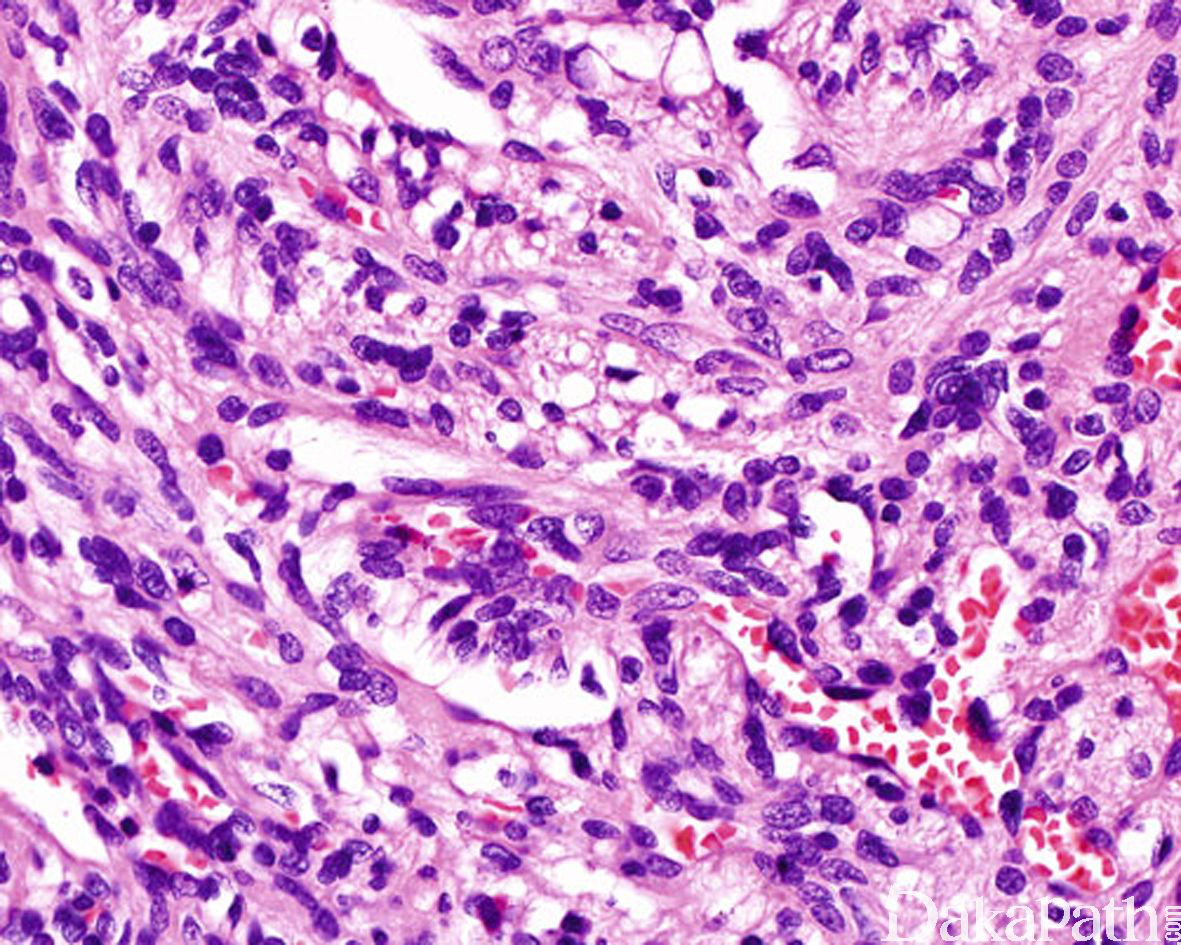

梭形细胞血管瘤
Spindle Cell Hemangioma,SCH
同义词(或曾用名): 梭形细胞血管内皮细胞瘤
概述:
是一种发生于浅表软组织的血管肿瘤,由海绵状血管瘤样区域和实性梭形细胞区域组成。
发病部位: 四肢的远端,部分病例也可位于躯干及头颈部等处
诊断要点:
可发生于任何年龄,多发生于四肢的远端;半数左右孤立单发,50%多发,多发性病变通常位于同一解剖部位;
病变直径较小,通常< 2cm, 位于真皮或皮下,偶尔可位于深部软组织,组织学呈多结节状生长,主要由海绵状血管瘤样区域和实性梭形细胞区域两种成分组成,梭形细胞成分达 50%以上;
海绵状血管瘤样区域内的血管多为扩张的薄壁血管,大小不一,内衬扁平内皮细胞,常充满血液,可伴血栓形成;
实性区域梭形细胞多和海绵状血管瘤样区域相互交融,梭形细胞呈短束状排列,其中血管或为扩张的薄壁血管,或呈不规则裂隙样,间质内常可见外渗的红细胞,类似卡波西肉瘤;
除梭形细胞外,实性区域内还可见小簇分布的圆形空泡状细胞,形态与上皮样血管内皮瘤中的空泡状细胞相似,似形成原始性脉管腔,当空泡状细胞数量较多时可类似于脂肪母细胞;瘤细胞核温和,少数可见退变的核非典型性,核分裂象罕见(< 1/50HPF);
约 50%的梭形细胞血管瘤可见肿瘤于血管内生长,10-20%的梭形细胞血管瘤可完全位于血管内。取决于血管瘤样成分和梭形细胞成分的比例多少,梭形细胞血管瘤在低倍镜下可能类似于海绵状血管瘤或 Kaposi 血管肉瘤;

免疫组织化学染色:
梭形细胞具有纤维母细胞性属性表达 vimentin 和 MSA,不表达 HHV8 和内皮细胞标志物;内皮细胞表达 CD31 和 CD34. ERG。网状纤维染色和勾勒出实行区域挤压的血管结构。
分子标记:
部分病例可见 R132C IDH1 突变
鉴别诊断:
海绵状血管瘤:肿瘤中多无实性的梭形细胞成分及空泡状上皮样的内皮细胞。
血管内乳头状内皮增生 :多无明显的实性梭形细胞区域。
Kaposi 肉瘤 :极少含有海绵状血管瘤样区域,瘤细胞中不含成巢或成簇的圆形空泡状细胞,免疫组化染色 HHV8 阳性。
预后:
良性血管病变,但多灶性病变易复发,复发率约 50%,无转移潜能。
治疗:
局部切除
病例报道:
Tosios K I, Gouveris I, Sklavounou A, et al. Spindle cell hemangioma (hemangioendothelioma) of the head and neck: case report of an unusual (or underdiagnosed) tumor.[J]. Oral Surg Oral Med Oral Pathol Oral Radiol Endod, 2008, 105(2):216-221. 参考文献:
Perkins P, Weiss SW. Spindle cell hemangioendothelioma. An analysis of 78 cases with reassessment of its pathogenesis and biologic behavior. Am J Surg Pathol. 1996;20:1196–1204. Kurek KC, Pansuriya TC, van Ruler MA, et al. R132C IDH1 mutations are found in spindle cell hemangiomas and not in other vascular tumors or malformations. Am J Pathol. 2013;182: 1494–1500.
← 血管瘤病 Kaposi型血管内皮瘤 →
